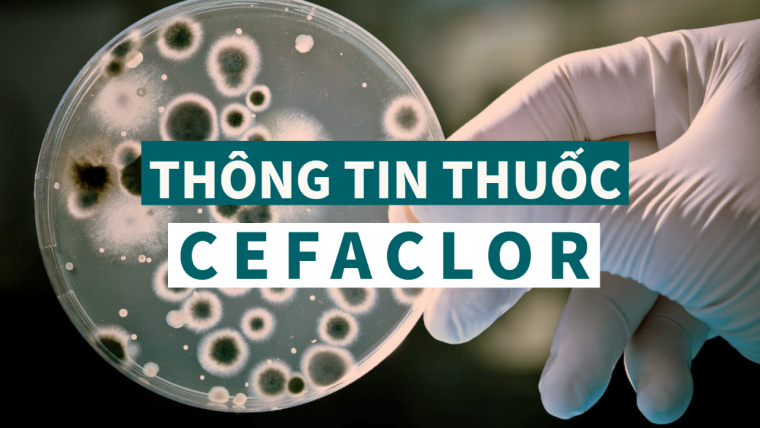
Cefaclor: Thông tin kháng sinh, chỉ định, chống chỉ định, tác dụng phụ và liều lượng

Tổng quan
Cefaclor là một cephalosporin thế hệ thứ hai được sử dụng để điều trị nhiều loại bệnh nhiễm trùng trong cơ thể. Tương tự Cefazolin, Cefaclor là dẫn xuất bán tổng hợp của cephalexin. Thuốc có phổ kháng khuẩn rộng.
Cấu trúc hóa học của Cefaclor
Chỉ định
Để điều trị một số bệnh nhiễm trùng do vi khuẩn gây ra như viêm phổi và nhiễm trùng tai, phổi, da, cổ họng và đường tiết niệu.
Phổ kháng khuẩn của Cefaclor bao gồm các tụ cầu và liên cầu gram dương.
Dược lực học
Cefaclor là kháng sinh cephalosporin thế hệ thứ hai, với phổ tương tự như cephalosporin thế hệ thứ nhất. Các thử nghiệm in vitro chứng minh rằng, tác dụng diệt khuẩn của cephalosporin là kết quả của việc ức chế tổng hợp thành tế bào. Theo chỉ định của các nghiên cứu lâm sàng in vitro và in vivo, cefaclor đã được chứng minh là có hiệu quả chống lại hầu hết các chủng vi khuẩn Gram dương - Staphylococci (bao gồm cả coagulase dương tính, coagulase âm tính và các chủng sản xuất penicillinase), Streptococcus pneumoniae, Streptococcus pyogenes (nhóm Liên cầu khuẩn tan huyết A), cũng như vi khuẩn Gram âm - Escherichia coli, Haemophilus influenzae (bao gồm các chủng kháng ampicillin sản xuất ß-lactamase), Klebsiella sp, và Proteus mirabilis.
Cơ chế tác dụng
Cefaclor, giống như penicillin, là một loại kháng sinh beta-lactam. Bằng cách liên kết với các protein liên kết penicilin cụ thể (PBPs) nằm bên trong thành tế bào vi khuẩn, nó ức chế giai đoạn thứ ba và giai đoạn cuối của quá trình tổng hợp thành tế bào vi khuẩn. Quá trình ly giải tế bào sau đó được thực hiện qua trung gian của các enzym tự phân giải thành tế bào vi khuẩn như autolysin. Có thể cefaclor cản trở chất ức chế autolysin.
Thời gian bán thải
Khoảng 0,6-0,9 giờ
Tác dụng phụ
- Tiêu chảy
- Ngứa hoặc tiết dịch âm đạo.
Liều lượng
Viêm đường hô hấp trên
- Người lớn: 250 đến 500 mg uống mỗi 8 giờ
- Điều trị theo kinh nghiệm: Ít nhất 48 đến 72 giờ sau khi bệnh nhân không có triệu chứng HOẶC thu được bằng chứng diệt trừ vi khuẩn
- Viêm xoang cấp tính do vi khuẩn: 10 ngày
- Nhiễm khuẩn liên cầu nhóm A (GAS): Ít nhất 10 ngày
Viêm phế quản
- Người lớn: 250 đến 500 mg uống mỗi 8 giờ
- Điều trị theo kinh nghiệm: Ít nhất 48 đến 72 giờ sau khi bệnh nhân không có triệu chứng HOẶC thu được bằng chứng diệt trừ vi khuẩn
- Viêm xoang cấp tính do vi khuẩn: 10 ngày
- Nhiễm khuẩn liên cầu nhóm A (GAS): Ít nhất 10 ngày
Trẻ em
- Công thức IR: 20 mg 40 mg / kg mỗi ngày bằng đường uống, cứ 8 đến 12 giờ một lần
- Liều tối đa: 1 gam / ngày
Thời gian điều trị:
- Điều trị theo kinh nghiệm: Ít nhất 48 đến 72 giờ sau khi bệnh nhân không có triệu chứng HOẶC thu được bằng chứng diệt trừ vi khuẩn
- Viêm xoang cấp tính do vi khuẩn: 10 ngày
- Nhiễm trùng GAS: Ít nhất 10 ngày
Viêm tai giữa
- Người lớn: 250 đến 500 mg uống mỗi 8 giờ
- Điều trị theo kinh nghiệm: Ít nhất 48 đến 72 giờ sau khi bệnh nhân không có triệu chứng HOẶC thu được bằng chứng diệt trừ vi khuẩn
- Viêm xoang cấp tính do vi khuẩn: 10 ngày
- Nhiễm khuẩn liên cầu nhóm A (GAS): Ít nhất 10 ngày
- Trẻ từ 1 tháng tuổi trở lên: 20 mg đến 40 mg / kg mỗi ngày bằng đường uống, cứ 8 đến 12 giờ một lần
- Liều tối đa: 1 gam / ngày
Thời gian điều trị:
- Điều trị theo kinh nghiệm: Ít nhất 48 đến 72 giờ sau khi bệnh nhân không có triệu chứng HOẶC thu được bằng chứng diệt trừ vi khuẩn
- Viêm xoang cấp tính do vi khuẩn: 10 ngày
- Nhiễm trùng GAS: Ít nhất 10 ngày
Viêm phổi
- Người lớn: 250 đến 500 mg uống mỗi 8 giờ
- Điều trị theo kinh nghiệm: Ít nhất 48 đến 72 giờ sau khi bệnh nhân không có triệu chứng HOẶC thu được bằng chứng diệt trừ vi khuẩn
- Viêm xoang cấp tính do vi khuẩn: 10 ngày
- Nhiễm khuẩn liên cầu nhóm A (GAS): Ít nhất 10 ngày
- Trẻ em: 20 mg 40 mg / kg mỗi ngày bằng đường uống, cứ 8 đến 12 giờ một lần
- Liều tối đa: 1 gam / ngày
Thời gian điều trị:
- Điều trị theo kinh nghiệm: Ít nhất 48 đến 72 giờ sau khi bệnh nhân không có triệu chứng HOẶC thu được bằng chứng diệt trừ vi khuẩn
- Viêm xoang cấp tính do vi khuẩn: 10 ngày
- Nhiễm trùng GAS: Ít nhất 10 ngày
Nhiễm trùng da và cấu trúc da, mô mềm
- Người lớn: 250 đến 500 mg uống mỗi 8 giờ
- Điều trị theo kinh nghiệm: Ít nhất 48 đến 72 giờ sau khi bệnh nhân không có triệu chứng HOẶC thu được bằng chứng diệt trừ vi khuẩn
- Trẻ em: 20 mg 40 mg / kg mỗi ngày bằng đường uống, cứ 8 đến 12 giờ một lần
- Liều tối đa: 1 gam / ngày
Thời gian điều trị:
- Điều trị theo kinh nghiệm: Ít nhất 48 đến 72 giờ sau khi bệnh nhân không có triệu chứng HOẶC thu được bằng chứng diệt trừ vi khuẩn
Viêm amidan/Viêm thanh quản
- Người lớn: 250 đến 500 mg uống mỗi 8 giờ
- Điều trị theo kinh nghiệm: Ít nhất 48 đến 72 giờ sau khi bệnh nhân không có triệu chứng HOẶC thu được bằng chứng diệt trừ vi khuẩn
- Viêm xoang cấp tính do vi khuẩn: 10 ngày
- Nhiễm khuẩn liên cầu nhóm A (GAS): Ít nhất 10 ngày
- Trẻ từ 1 tháng tuổi trở lên: 20 mg đến 40 mg / kg mỗi ngày bằng đường uống, cứ 8 đến 12 giờ một lần
- Liều tối đa: 1 gam / ngày
Thời gian điều trị:
- Điều trị theo kinh nghiệm: Ít nhất 48 đến 72 giờ sau khi bệnh nhân không có triệu chứng HOẶC thu được bằng chứng diệt trừ vi khuẩn
- Viêm xoang cấp tính do vi khuẩn: 10 ngày
- Nhiễm trùng GAS: Ít nhất 10 ngày
Viêm bể thận
- Người lớn: 250 đến 500 mg uống mỗi 8 giờ
- Điều trị theo kinh nghiệm: Ít nhất 48 đến 72 giờ sau khi bệnh nhân không có triệu chứng HOẶC thu được bằng chứng diệt trừ vi khuẩn
- Trẻ em: 20 mg 40 mg / kg mỗi ngày bằng đường uống, cứ 8 đến 12 giờ một lần
- Liều tối đa: 1 gam / ngày
Thời gian điều trị:
- Điều trị theo kinh nghiệm: Ít nhất 48 đến 72 giờ sau khi bệnh nhân không có triệu chứng HOẶC thu được bằng chứng diệt trừ vi khuẩn
Viêm đường tiết niệu
- Người lớn: 250 đến 500 mg uống mỗi 8 giờ
- Điều trị theo kinh nghiệm: Ít nhất 48 đến 72 giờ sau khi bệnh nhân không có triệu chứng HOẶC thu được bằng chứng diệt trừ vi khuẩn
- Trẻ em: 20 mg 40 mg / kg mỗi ngày bằng đường uống, cứ 8 đến 12 giờ một lần
- Liều tối đa: 1 gam / ngày
Thời gian điều trị:
- Điều trị theo kinh nghiệm: Ít nhất 48 đến 72 giờ sau khi bệnh nhân không có triệu chứng HOẶC thu được bằng chứng diệt trừ vi khuẩn
Viêm bàng quang
- 20 mg 40 mg / kg mỗi ngày bằng đường uống, cứ 8 đến 12 giờ một lần
- Liều tối đa: 1 gam / ngày
Thời gian điều trị:
- Điều trị theo kinh nghiệm: Ít nhất 48 đến 72 giờ sau khi bệnh nhân không có triệu chứng HOẶC thu được bằng chứng diệt trừ vi khuẩn
- 16 tuổi trở lên:Viên nén ER: 375 mg uống mỗi 12 giờ
- Liều tối đa: 750 mg / ngày
- Thời gian điều trị: 7 đến 10 ngày
Phụ nữ có thai và cho con bú
Chỉ nên sử dụng nếu thật cần thiết và lợi ích cao hơn nguy cơ.
AU TGA hạng mục mang thai: B1
FDA Hoa Kỳ mang thai loại: B
Các nghiên cứu trên động vật đã không phát hiện được bằng chứng về độc tính phôi thai, nhiễm độc thai nghén, nhiễm độc thai nhi, gây hại cho thai nhi, suy giảm khả năng sinh sản, quái thai, nhiễm độc phôi thai. Tuy nhiên, có sự gia tăng nhẹ về dị dạng xương nhỏ khi các mô hình động vật được sử dụng liều cao (500 mg / kg). Không có dữ liệu được kiểm soát trong quá trình mang thai ở người.
AU TGA cho thai kỳ loại B1: Thuốc chỉ được dùng cho một số ít phụ nữ có thai và phụ nữ trong độ tuổi sinh đẻ mà không làm tăng tần suất dị tật hoặc các tác động có hại trực tiếp hoặc gián tiếp khác đối với thai nhi đã được quan sát thấy. Các nghiên cứu trên động vật không cho thấy bằng chứng về sự gia tăng các tổn thương thai nhi.
FDA Hoa Kỳ mang thai loại B: Các nghiên cứu về sinh sản trên động vật đã không chứng minh được nguy cơ đối với thai nhi và không có nghiên cứu đầy đủ và được kiểm soát tốt ở phụ nữ mang thai.
Một lượng nhỏ lên đến 0,21 mcg / mL đã được phát hiện trong sữa mẹ đến 5 giờ sau khi dùng một liều uống 500 mg.
Thận trọng được khuyến khích.
Bài tiết vào sữa mẹ: Có
Bình luận:
- Học viện Nhi khoa Hoa Kỳ coi các cephalosporin khác (ví dụ: cefadroxil, cefazolin) tương thích với việc cho con bú.
- Liều cephalosporin của bà mẹ đã dẫn đến các báo cáo về tiêu chảy và tưa miệng ở trẻ sơ sinh.
Xem thêm thông tin về Cefaclor dưới dạng video tại đây: